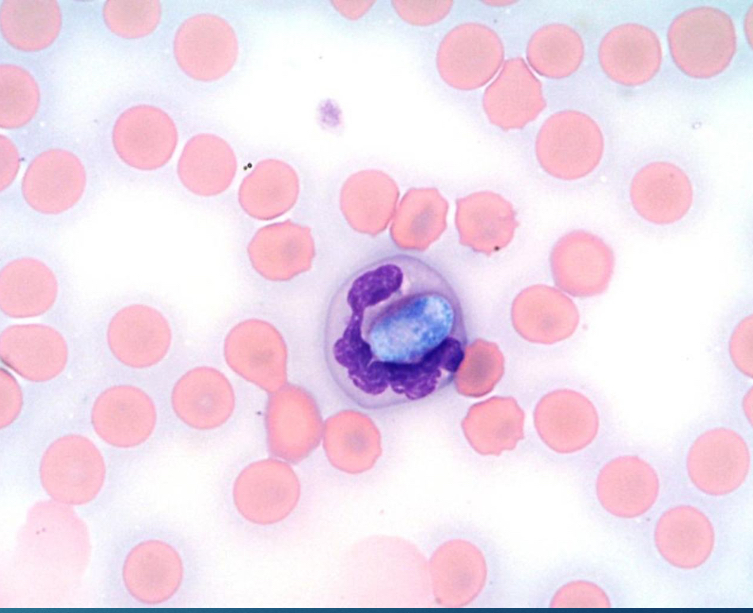
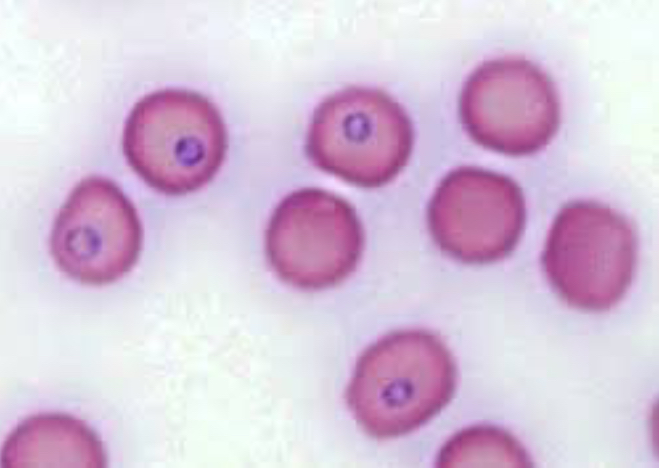
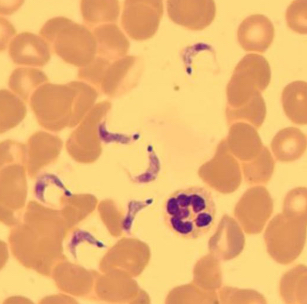

flatworms & protozoans parasites
1/43
There's no tags or description
Looks like no tags are added yet.
Name | Mastery | Learn | Test | Matching | Spaced |
|---|
No study sessions yet.
44 Terms
Hepatozoon canis/ americanum
Hepatazoonosis
Hepatozoon canis/ americanum
Blood smear
Cytauxzoon felis
Cytauxzoonosis
Cytauxzoon felis
Blood smear
Theileria spp.
Equine piroplasm
Theileria spp.
Blood smear of horses

Babesia canis/ bigemina
Babesia or canine piroplasm
Babesia canis/ bigemina
Blood smear of dog or cattle

Leishmania spp.
Leishmania
Leishmania spp.
Skin scraping of cutaneous lesions of lymph nodes, spleen, bone marrow, or other tissues

Trypanosoma cruzi
Trypanosome
Trypanosoma cruzi
Blood smear
Tritrichomonas foetus
Trichomonas
Tritrichomonas foetus
Fluid from stomach of aborted fetus or uterine discharge

Cryptosporidium spp.
Crypto
Cryptosporidium spp.
Stained fecal smear

Toxoplasma gondii
Toxoplasma
Toxoplasma gondii
Rare in fecal flotation

Eimeria spp.
Coccidiosis
Eimeria spp.
Fecal flotation with zinc sulfate

Cytoisospora spp
Coccidiosis
Cystoisospora spp.
Fecal flotation with zinc sulfate

Balantidium coli
Balantidium
Balantidium coli
Fecal flotation or direct smear

Giardia spp.
Giardia
Giardia spp.
fecal flotation or direct smear

Paragonimus kellicoti
Lung fluke
Paragonimus kellicoti
Fecal flotation or sedimentation

Nanophyetus salmincola
Salmon poisoning fluke
Nanophyetus salmincola
Fecal sedimentation or centrifugation with sheather’s

Fasciola hepatica
Liver fluke
Fasciola hepatica
Fecal sedimentation

Anolocephala spp
Equine tapeworm
Anolocephala spp.
Fecal flotation

Moniezia spp.
Ruminant tapeworms
Moniezia spp.
Fecal flotation

Echinococcus spp.
Uniocuoar/multiocular Hydatid tapeworm
Taenia spp.
Tapeworm
Diplyidium caninum
Cucumber seed tapeworm
Diplylidium caninum
In feces or on fecal flotation of dogs or cats

Taenia spp.
In feces or segment squash from dogs

Echinococcus spp.
usually small so find adult in GI of dogs or cats

Spirometra mansonoides
zipper or sparganosis tapeworm
Diphyllobothrium latum
Broad fish tapeworm